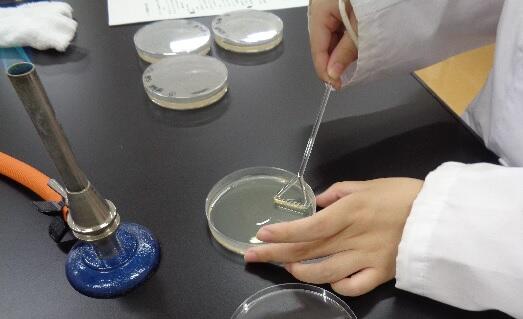

品質管理流通科
殺菌効果を調べる
品質管理流通科3年生は応用微生物の実習で殺菌効果があるといわれて販売されている
商品などの殺菌効果を調べました。
標準寒天培地を作りその上に納豆菌をたっぷり含んだ水をコンラージ棒で塗り広げて
その中心に殺菌剤を落としどれだけ納豆菌の繁殖が妨げられるかで
その薬剤などの殺菌効果を調べる実験です。
結果は納豆菌の培養のため一定温度で48時間経たないとわかりませんが
今から結果が楽しみだと生徒たちは楽しそうに話していました。
ちなみに世の中にある殺菌効果のある物にはそれぞれ菌や使用環境などに対して
向き不向きがあるので一概に効果があるから良いとか悪いとかと判断はできません。